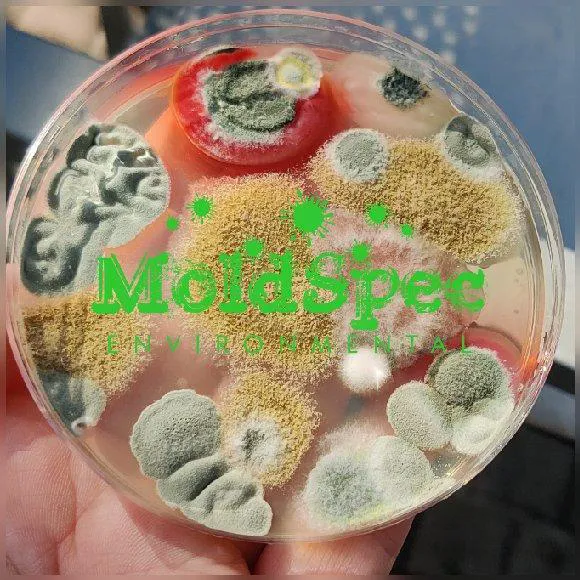
MoldSpec Environmental LLC Picture 9

In the dynamic and often challenging environment of Florida real estate, both for buyers and long-term owners, unseen dangers lurk beneath the surface—most commonly hidden water damage and insidious mold growth. These issues, if missed, can quickly turn a significant investment into a financial catastrophe. To navigate this risk, the Florida community needs a specialized contractor, an expert whose primary function is integrity and meticulous detection. MoldSpec Environmental LLC fulfills this vital role, operating as an indispensable Home Inspector and Restoration Service specializing in pinpointing and addressing the moisture-related issues so common in the Sunshine State.
MoldSpec’s approach transcends the typical home inspection. They are experts in environmental assessment, focusing on crucial components like Indoor Air quality and the integrity of Building Materials. For anyone under contract to purchase a home or concerned about a recurring Leak Detection issue, their specialized findings can save thousands, often uncovering hidden damage that general inspectors miss entirely. They function as a necessary safeguard against property neglect and the spread of toxic mold infestation. Furthermore, their experience extends into full Fire damage restoration service and Water damage restoration service, meaning they not only identify the problem but understand the full scope of remediation and renovation required, providing clients with a realistic and honest view of the situation. They are, simply put, essential in the Floridian environment we live in.
MoldSpec Environmental LLC is strategically located in Port St. Lucie, allowing them to serve the Treasure Coast and surrounding communities with the speed required for both urgent inspections and post-damage assessments. When time is critical—either during a property transaction or following a Pipe Break—a local presence ensures prompt dispatch.
The location details and attention to client accessibility ensure that all customers can easily connect with the company for reports, consultations, or scheduling needs.
- The operational address is 1734 SW Millikin Ave, Port St. Lucie, FL 34953, USA, facilitating rapid access to the local residential and commercial markets.
- The facility provides a dedicated Wheelchair accessible parking lot, demonstrating a commitment to professional courtesy and accessibility for all clients.
- Clients can conveniently initiate service requests and receive preliminary information via Online estimates, streamlining the initial contact process during often-stressful situations.
The service structure of MoldSpec is built around comprehensive inspection, specialized sampling, and professional restoration capabilities, providing the specialized general contractor services required for addressing the full spectrum of water and mold damage issues in Florida properties.
- Advanced Inspection and Testing Services: This critical specialization includes Mold Inspection And Mold Test, General Home Inspection, and Specialized Inspection. They utilize scientific methods such as Mold Assessments, Mold Sampling, Swab Sampling, and Indoor allergen sampling to identify threats like Black Mold and other Toxic Molds. They also focus on systems like Hvac Systems and Indoor Air quality.
- Moisture and Leak Detection: Focusing on the source of property damage, services include Leak Detection to find hidden Pipe Break and Roof Leaks. They specialize in assessing Water Damaged areas resulting from various Water leaks to determine the necessary scope of remediation.
- Environmental Verification and Sanitization: Following remediation by a Licensed Mold Remediation professional, they perform Post Remediation Verification and Clearance Testing—a necessary step to legally verify a Mold Problem has been resolved. They also provide Sanitizing Services and Indoor Air Sanitizing.
- Comprehensive Restoration Capabilities: While specializing in inspection, their capabilities extend to the full recovery process, including Water damage restoration service, Fire damage restoration service, and all necessary Fire damage cleanup & repair services. They understand the entire scope of work required after a property loss event.
- Client Education and Consultation: Their services include detailed reporting and consultation to ensure clients fully understand the findings of the Mold Inspections and the implications for the Building Materials involved.
The core value proposition of MoldSpec Environmental LLC is built on their unparalleled expertise and commitment to ethical practice, resulting in direct financial protection and peace of mind for the client, as evidenced by local testimonials.
- Proven Financial Loss Prevention: Customers have shared powerful examples of the company’s ability to save them from major financial losses, uncovering hidden damage and neglect totaling tens of thousands of dollars that primary inspectors had missed. This expertise is described as super professional and "very necessary in the Floridian environment."
- Expertise and Integrity: Led by experts like Abriel, the team is consistently described as professional, courteous, punctual, and extremely thorough. Clients emphasize that the experts are honest throughout the process and take immense pride in their work, establishing MoldSpec as a reliable source of truth in property assessment.
- Specialized Mold Certification: The company employs Certified Mold Inspectors and uses advanced techniques, including Mold Sampling and Clearance Testing, essential for definitively proving a property is free of fungal contamination and addressing Mold Problem concerns.
- Comprehensive Findings: Their inspections go far beyond the scope of a Typical Home Inspection, pointing out critical issues often overlooked, leading to invaluable knowledge that prevents investing into a money pit.
- Seamless Service Initiation: The availability of Online estimates allows clients, especially those involved in fast-moving real estate contracts, to quickly obtain necessary information and schedule an inspection ASAP.
For Port St. Lucie residents and buyers needing an emergency inspection, mold testing, or specialized restoration consultation, MoldSpec Environmental LLC can be reached immediately via the following contacts.
- Address: 1734 SW Millikin Ave, Port St. Lucie, FL 34953, USA
- Phone: (954) 336-0417
- Mobile Phone for direct communication and urgent scheduling: +1 954-336-0417
In the uniquely challenging world of Florida property ownership, MoldSpec Environmental LLC offers something invaluable: definitive, honest, and expert assurance. Choosing this company is about proactive financial protection, given their demonstrated ability to uncover hidden damage, including Toxic Molds and extensive Water Damaged areas, that can cost tens of thousands in unexpected remediation and renovation. They operate with an impressive level of professionalism, combining the integrity of a dedicated Home Inspector with the crucial knowledge of a Licensed Mold Remediation contractor. For any Florida resident buying a property or dealing with the uncertainty of a Pipe Break or Roof Leaks, the decision is clear: their specialized Inspection Services, combined with the final verification of Clearance Testing and their expertise in restoration, make them the single most important call to safeguard your investment, saving you a lot of heartache and financial loss. They are truly amazing and very necessary, protecting the community one property at a time.

Flood Pros USA4.0 (33 reviews)
Jim Black Construction Inc4.0 (185 reviews)
Indiana Foundation Service4.0 (1700 reviews)
Ajaxx Restoration5.0 (33 reviews)
The Water Damage Pros Charlotte4.0 (18 reviews)
ServiceMaster Recovery Services by 24/7/3655.0 (11 reviews)
Water Damage Repair for Subflooring Under Carpets
How to Handle Water Damage After a Storm: A Step-by-Step Guide
Water Damage Restoration for Restaurants and Food Service Areas – A Complete Guide
How to Deal With Water Damage From Roof Ice Dams: Prevention and Repair Tips
What to Do if Your Roof Is Leaking and Causing Water Damage Inside
How to Restore Water-Damaged Rugs and Carpets